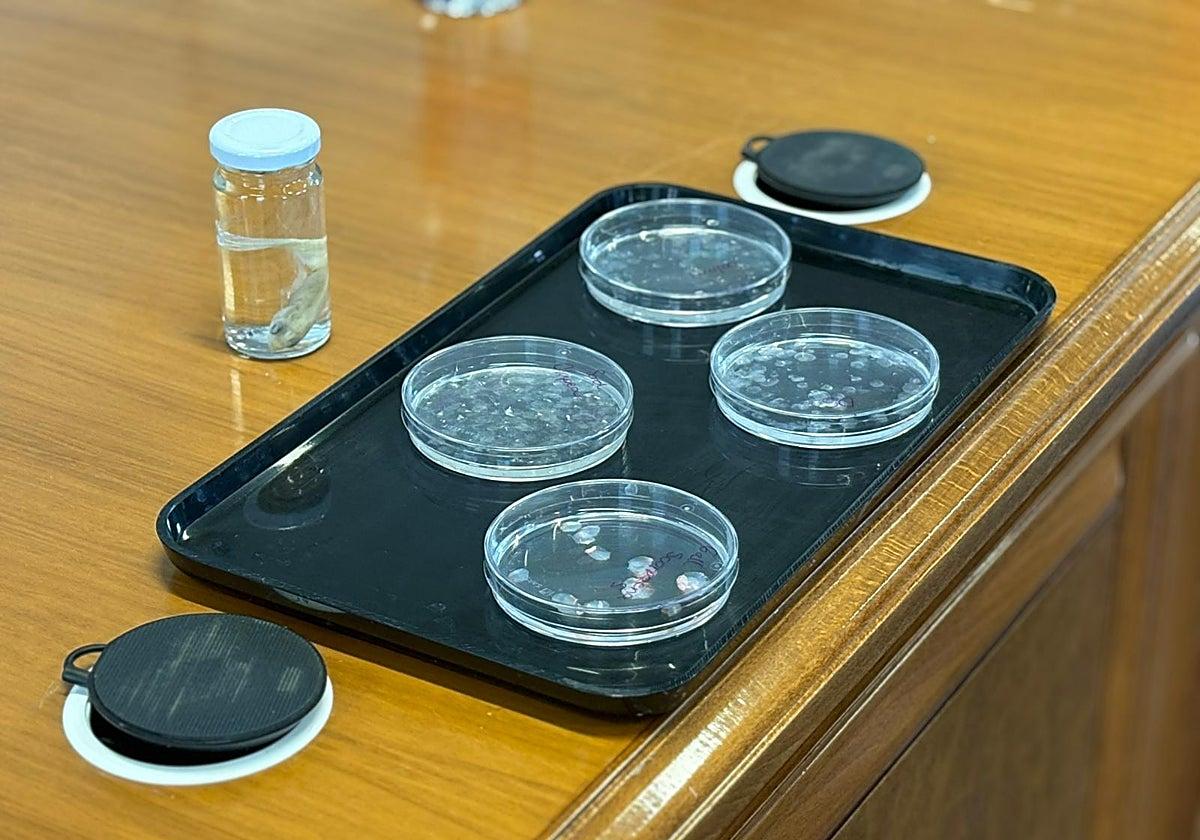
Spanyol kutatók halpikkelyből fejlesztettek szaruhártya-implantátumot

Spanyol kutatók halpikkelyből fejlesztettek szaruhártya-implantátumot
A spanyol tudósok olyan szaruhártya-implantátumot fejlesztettek, amely halpikkelyből készül, és laboratóriumi, valamint állatkísérletekben ígéretes eredményeket mutatott.
A kutatás azt sugallja, hogy a jövőben csökkenthető lehet az átültetésekhez szükséges donorszövetektől való függőség.
Kidobott halpikkelyekből készülhet orvosi implantátum
A kutatók évek óta vizsgálják ezt az eddig alig hasznosított mellékterméket. A ponty és más gyakran fogyasztott halak pikkelyeinek elemzésével sikerült olyan biomateriált létrehozniuk, amely:
-
biológiailag kompatibilis az emberi szervezettel
-
tartós
-
átlátszó, így alkalmas a szaruhártya pótlására
A szaruhártya – a szem elülső, átlátszó rétege – súlyos károsodás esetén nehezen kezelhető. Mivel nincs közvetlen vérellátása és rosszul regenerálódik, az orvosok sok esetben csak szaruhártya-átültetéssel tudnak segíteni.
Azonban a donorszövet rendkívül kevés, miközben a betegek száma folyamatosan nő.
„Új, hatékony regenerációs módszerekre van szükség, amelyek nem függnek a donorszervektől” – mondta Miguel Alaminos, a Granadai Egyetem hisztológia professzora és a kutatás egyik vezetője.
Olcsó és könnyen elérhető alapanyag
A kutatás – amely a Materials & Design folyóiratban jelent meg – részletesen bemutatja, hogyan sikerült a halpikkelyekből olyan biomateriált létrehozni, amely alkalmas lehet a szaruhártya helyreállítására.
A tesztek laboratóriumban és állatkísérletekben jó működési eredményeket mutattak.
A kutatók szerint a módszer egyik nagy előnye az, hogy az alapanyag rendkívül olcsó és könnyen beszerezhető.
A halpikkelyek a halászati ipar melléktermékei, amelyeket sok esetben egyszerűen kidobnak. Ha azonban orvosi implantátumok alapanyagává válnának, az új gazdasági lehetőségeket is teremthetne.
„Ez az alapanyag könnyen hozzáférhető, egyszerűen feldolgozható és olcsó, így akár a halászati ágazatnak is lendületet adhat” – mondta Ingrid Garzón, a Granadai Egyetem kutatója.
Még hosszú az út a klinikai alkalmazásig
Bár az eredmények biztatóak, a kutatás még korai szakaszban van.
A laboratóriumi és állatkísérletek sikeresen lezárultak, de mielőtt az implantátumokat embereken is alkalmazhatnák, klinikai vizsgálatokra van szükség. Ez általában több évig tart, és szigorú szabályozás mellett zajlik.
A kutatók szerint azonban már most sikerült bizonyítani, hogy a halpikkelyből készült anyag biológiai és szerkezeti szempontból alkalmas lehet a szaruhártya pótlására.
Bár még nem biztos, hogy a ponty pikkelyéből készült szaruhártya hamarosan megjelenik a műtőkben, az eredmények egy olyan új lehetőséget mutatnak, amely segíthet enyhíteni a globális donorszövet-hiányt.

Még nincsenek hozzászólások. Legyél te az első!